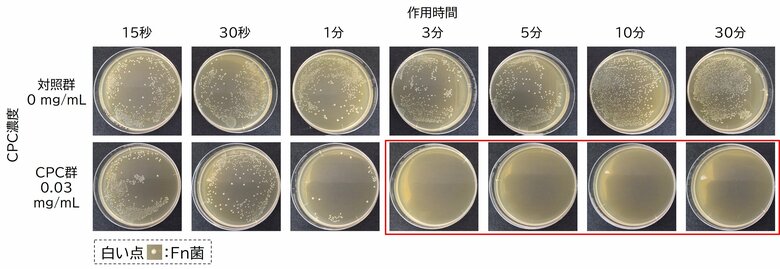
“菌” に着目した口臭ケアで、ドブ臭！？生ごみ臭！？とサヨナラ！～CPCによる口臭原因菌の殺菌効果を検証～

プレスリリース配信元:大正製薬株式会社
春は新しい出会いが増える季節。初対面の場で、服装や髪形などの身だしなみに気を配る方は多いと思います。しかし、意外と忘れがちなのが口臭対策です。自分自身では気づきにくいからこそ、事前の準備が大切です。
そこで、今回は口臭に対する意識調査の結果を紹介するとともに、口臭原因菌に着目した対策法をご紹介します。
<概要>
● 意識調査の結果、自分の口臭を意識している方は約6割と、多くの方が口臭を気にかけている。
●口臭の原因となるFn菌(F.nucleatum菌)は、誰の口にも存在しうる。
●CPC(セチルピリジニウム塩化物水和物)がFn菌を殺菌する様子を『見える化』したデータを公開。
◆自分の口臭を意識する人は6割超
20~60代の男女に口臭に対する意識調査を実施した結果、自分の口臭について「いつも意識する」・「たまに意識する」と回答した人は62.3%でした。

また、自分の口臭を「意識する」と回答した人のうち、“他人”の口臭について「頻繁に気になる」・「ときどき気になる」と回答した割合は83%と高く、多くの方が自分の口臭と同じように他人の口臭も気になっていることが分かりました。
◆口臭の原因は“菌”だった?菌が増えるタイミングとは?
口臭の原因の一つに、口の中にいる「菌」が関係していることをご存じですか?
私たちの口の中には多くの細菌が存在します。その中でも、Fusobacterium nucleatum(略称:Fn菌)は、口臭原因菌としてよく知られ、どなたの口の中にも存在しうる菌です。Fn菌は、口臭の主な臭い成分である硫化水素(「ドブ」のようなにおい)やメチルメルカプタン(「生ごみ」のようなにおい)を作り出します。
今回実施した調査では、「自分の口臭が気になった場面」として、【緊張したとき】、【長時間水分を摂っていないとき】、【寝起き】の回答が多く集まりました。これは、これらの状況が口内の細菌増加と関係しているためと考えられます。具体的には、次のようなタイミングで菌が増えやすくなると考えられます。
1. 緊張したとき、長時間水分を摂っていないとき
水分を摂っていないときや、緊張やストレスを受けた時は口が乾きやすくなり、唾液量が減ります。唾液には細菌の増殖を抑える成分が含まれているため、唾液が減ることは口臭につながります。
2. 寝起き
就寝中は唾液分泌が減ることに加え、口の中の酸素量が減り、酸素を嫌う嫌気性菌が増えやすくなります。Fn菌は嫌気性菌のため、起床直後に口臭が強く感じられることが多いと考えられます。
菌が増えるタイミングが分かったところで、次は「菌を減らす方法」についてお教えします。
◆殺菌成分:CPCの殺菌効果を検証
口臭の原因となる菌を効果的に減らすためには、殺菌成分を取り入れることが重要です。
市販ののど飴やうがい薬などにも配合される殺菌成分『CPC』は細菌の細胞膜(脂質二重膜)を破壊することで、優れた殺菌効果を示すことが知られています。

今回は、このCPCが口臭原因菌(Fn菌)に対してどのように作用するのか、その効果を『見える化』した検証試験を行いました。
【実験手順】

【検証結果:CPCによる菌の減少推移】

上の画像は、Fn菌に対して「殺菌成分を含まない水(対照群)」と「CPC水溶液(CPC群)」を作用させ、時間の経過とともに菌がどのように変化するかを比較したものです。白い点が生きているFn菌のコロニーを示します。
l 対照群(上段 : 0 mg/mL)
15秒から30分経過後まで、いずれの時間でも多数の菌が残存しています。
l CPC群(下段 : 0.03 mg/mL)
作用させてから1分後には対照群に比べて菌が著しく減少しました。さらに、“3分以降(赤枠)では、菌が検出されない状態(殺菌された状態)”となりました。
この結果から、0.03 mg/mLの濃度のCPCを3分間維持することで、口臭原因菌であるFn菌を殺菌できることが視覚的に確認されました。
◆“菌”に着目した対処法
それでは、実際にどのような対処をすればよいのでしょうか。口臭の原因となる“菌”に着目した対処法をご紹介します。
1. CPCが配合されたのど飴、うがい薬、洗口液の活用
前の段でご説明した通り、CPCは口臭原因菌(Fn菌)を殺菌することができます。CPCが配合されたのど飴をはじめとする商品は、口臭対策におすすめです。
2. 定期的に口をゆすぐ
口が乾燥し唾液分泌が低下すると、口臭原因菌が増殖することが知られています。定期的に口をゆすぐことで、原因菌の増殖を抑えることができます。
3. 舌クリーニング
舌の表面には口臭原因菌が多く存在するといわれています。専用ブラシで舌苔を除去することで、物理的に口臭原因菌を減らすことができます。
◆まとめ
口臭を対策するには、原因となる“菌”にアプローチすることが重要です。今回の検証結果から、CPCによって口臭原因菌(Fn菌)が殺菌される様子を視覚的に確認することができました。
口臭を気にせず、笑顔で会話を楽しめるように。今日からできる口臭ケアを日常に取り入れて、出会いの季節を楽しみましょう。
【調査に関する概要】
調査実施会社:大正製薬株式会社
調査方法:インターネット調査(Surveroidを利用)
調査日:2025年12月24日~2025年12月25日
有効回答数:20~60代の男女、1003人
企業プレスリリース詳細へ
PR TIMESトップへ
データ提供 PR TIMES
本記事の内容に関するお問い合わせ、または掲載についてのお問い合わせは株式会社 PR TIMES (release_fujitv@prtimes.co.jp)までご連絡ください。また、製品・サービスなどに関するお問い合わせに関しましては、それぞれの発表企業・団体にご連絡ください。



